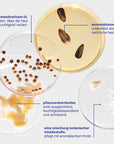
all-purpose moisture balm.
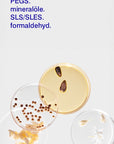
all-purpose moisture balm.

all-purpose moisture balm.
universal-feuchtigkeitsspender.
Ein intensiv pflegender, vielseitiger Balsam, der die Haut reichhaltig mit Feuchtigkeit versorgt und trockene, dehydrierte Haut am ganzen Körper beruhigt. Unterstützt nachweislich die Hautbarriere und spendet 12 Stunden lang Feuchtigkeit*.
WIRKUNG.
was es ist.
Unser intensiv pflegender, vielseitiger Feuchtigkeitsbalsam enthält 17 pflanzliche Inhaltsstoffe und Butter, die trockener, dehydrierter Haut gezielt Linderung verschaffen. Diese ultra-reichhaltige Formel beginnt als üppiger Balsam, der zu einem leichten, trockenen Öl schmilzt und so für wohltuende Feuchtigkeit ohne zu beschweren oder Rückstände zu hinterlassen sorgt. Sicher und wirksam von Kopf bis Fuß, ist es ein unverzichtbares Produkt für die Haut, das beruhigt, weich macht und Feuchtigkeit dort einschließt, wo Sie sie am meisten brauchen.
warum Sie es brauchen.
Dieser vielseitige Balsam spendet nicht nur Feuchtigkeit, sondern passt sich auch den Bedürfnissen Ihrer Haut an. Er ist reichhaltig und dennoch atmungsaktiv und wirkt überall und jederzeit gegen trockene Hautstellen, spröde Lippen, raue Nagelhaut und vieles mehr. Er ist in einer praktischen Aluminiumtube verpackt, lässt sich flexibel auftragen, leicht kombinieren und nahtlos in Ihre Pflegeroutine integrieren.
klinische ergebnisse*
+ Verbessert nachweislich die Hautbarriere + Feuchtigkeitsversorgung nach einmaliger Anwendung
+ 94 % Verbesserung der Hautglätte nach einmaliger Anwendung
+ 100 % stimmten zu, dass die Haut gesund aussieht
+ 100 % stimmten zu, dass sich die Haut nach der Anwendung weich und glatt anfühlt
+ 100 % stimmten zu, dass sich das Produkt nicht klebrig/fettig anfühlt
+ 100 % stimmen zu, dass das Produkt schnell in die Haut einzieht
*basierend auf einer klinischen Studie, die über einen Zeitraum von 12 Stunden an 34 Probanden mit verschiedenen Hauttypen durchgeführt wurde.
INHALTSSTOFFE.
+ Wiesenschaumkrautöl verhindert Feuchtigkeitsverlust und hinterlässt ein weiches, nicht fettendes Finish.
+ Sonnenblumenöl unterstützt die natürliche Barrierefunktion der Haut und speichert Feuchtigkeit.
+ Pflaumenkernölbutter spendet Feuchtigkeit, schützt und regeneriert die Haut.
+ Pflanzenkombination pflegt die Haut und sorgt für ein wohltuendes aromatisches Erlebnis.
ANWENDUNG.
Den Balsam zwischen den Fingern erwärmen und überall dort auftragen, wo die Haut zusätzliche Pflege benötigt.
universelle multi-pflege
+ gesicht. Trockene Lippen, Nase + Ohren, After-Sun-Pflege, Aftershave-Balsam, Bartpflegemittel, Make-up-Grundierung oder -Entferner, Nachtmaske, Augenbrauenpflege.
+ körper. Pflege für raue Ellbogen, Knie + Füße, Hand- + Nagelhautpflege, Tattoo-Pflege, Massageöl, verleiht strahlenden Glanz überall dort, wo die Haut das Licht einfängt, wie Beine, Schultern, Schlüsselbein + Lippenbogen.
+ haare. Glättet Spliss, bändigt fliegende Haare + verleiht Glanz.
Wird gerne zusammen gekauft:
Diese Angaben spiegeln unseren aktuellen Kenntnisstand wider. Inhaltsstoffe können von Zeit zu Zeit vom Hersteller angepasst werden. Wir empfehlen daher unbedingt vor Anwendung die entsprechenden Angaben auf der Produktverpackung zu berücksichtigen.